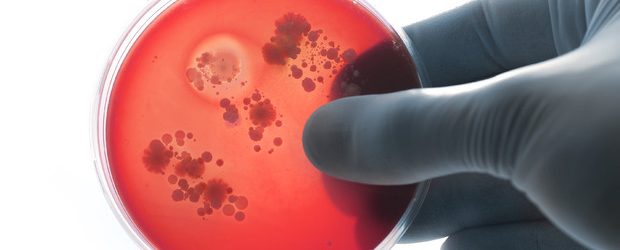
Benevento| Caso meningite: maestra fuori pericolo

E’ fuori pericolo la maestra d’asilo colpita da meningite batterica dieci giorni fa.La donna,una 30enne beneventana si era sentita male al rientro da scuola,un malessere che inizialmente aveva fatto pensare all’influenza, una condizione poi aggravata da convulsioni che hanno reso necessario il ricovero urgente all’ospedale Rummo. Al nosocomio sannita la diagnosi terribile:meningite batterica, da qui il trasferimento in elicottero all’ospedale Cotugno di Napoli, dove la maestra è rimasta in coma farmacologico fino a quando ha iniziato a respirare autonomamente e a riprendere finalmente conoscenza.Stubata e finalmente cosciente è stata sottoposta ad una Tac al cervello per verificarne le condizioni di salute,l’esame strumentale non ha evidenziato danni cerebrali.La giovane maestra e mamma di un bimbo di solo un anno (sottoposto a profilassi antibiotica come tutti i bambini dell’asilo) resterà ancora in osservazione per il tempo necessario a scongiurare ogni tipo di problema.